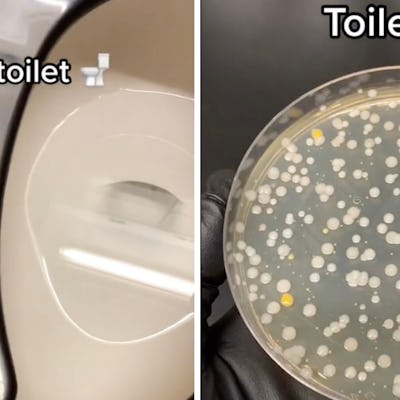

| ||||||||||||||||||||||||||||||||||||||||||||||||||||||||||||||||||||||||||||||||||||||||||||||||||||||||||||||||||||||||||||||||||||||||||||||||||||||||||||||||||||||
|
Friday, March 17, 2023
A Handy Guide To What The Heck Your Kid's Slang Means
Subscribe to:
Post Comments (Atom)
The Christmas Gifts We Can't Stop Talking About
Yes... still. Feb. 6, 2026 Worth The Hype 26 Christmas Gifts That Scary Mommy Editors Can't Stop Talking About Yes, we're st...
-
VN Official posted: "Audio: Mt. Joy- Orange Blood Mp3 Download, Video, 320kbps Audio Download & Lyrics Mt. Joy com...

No comments:
Post a Comment